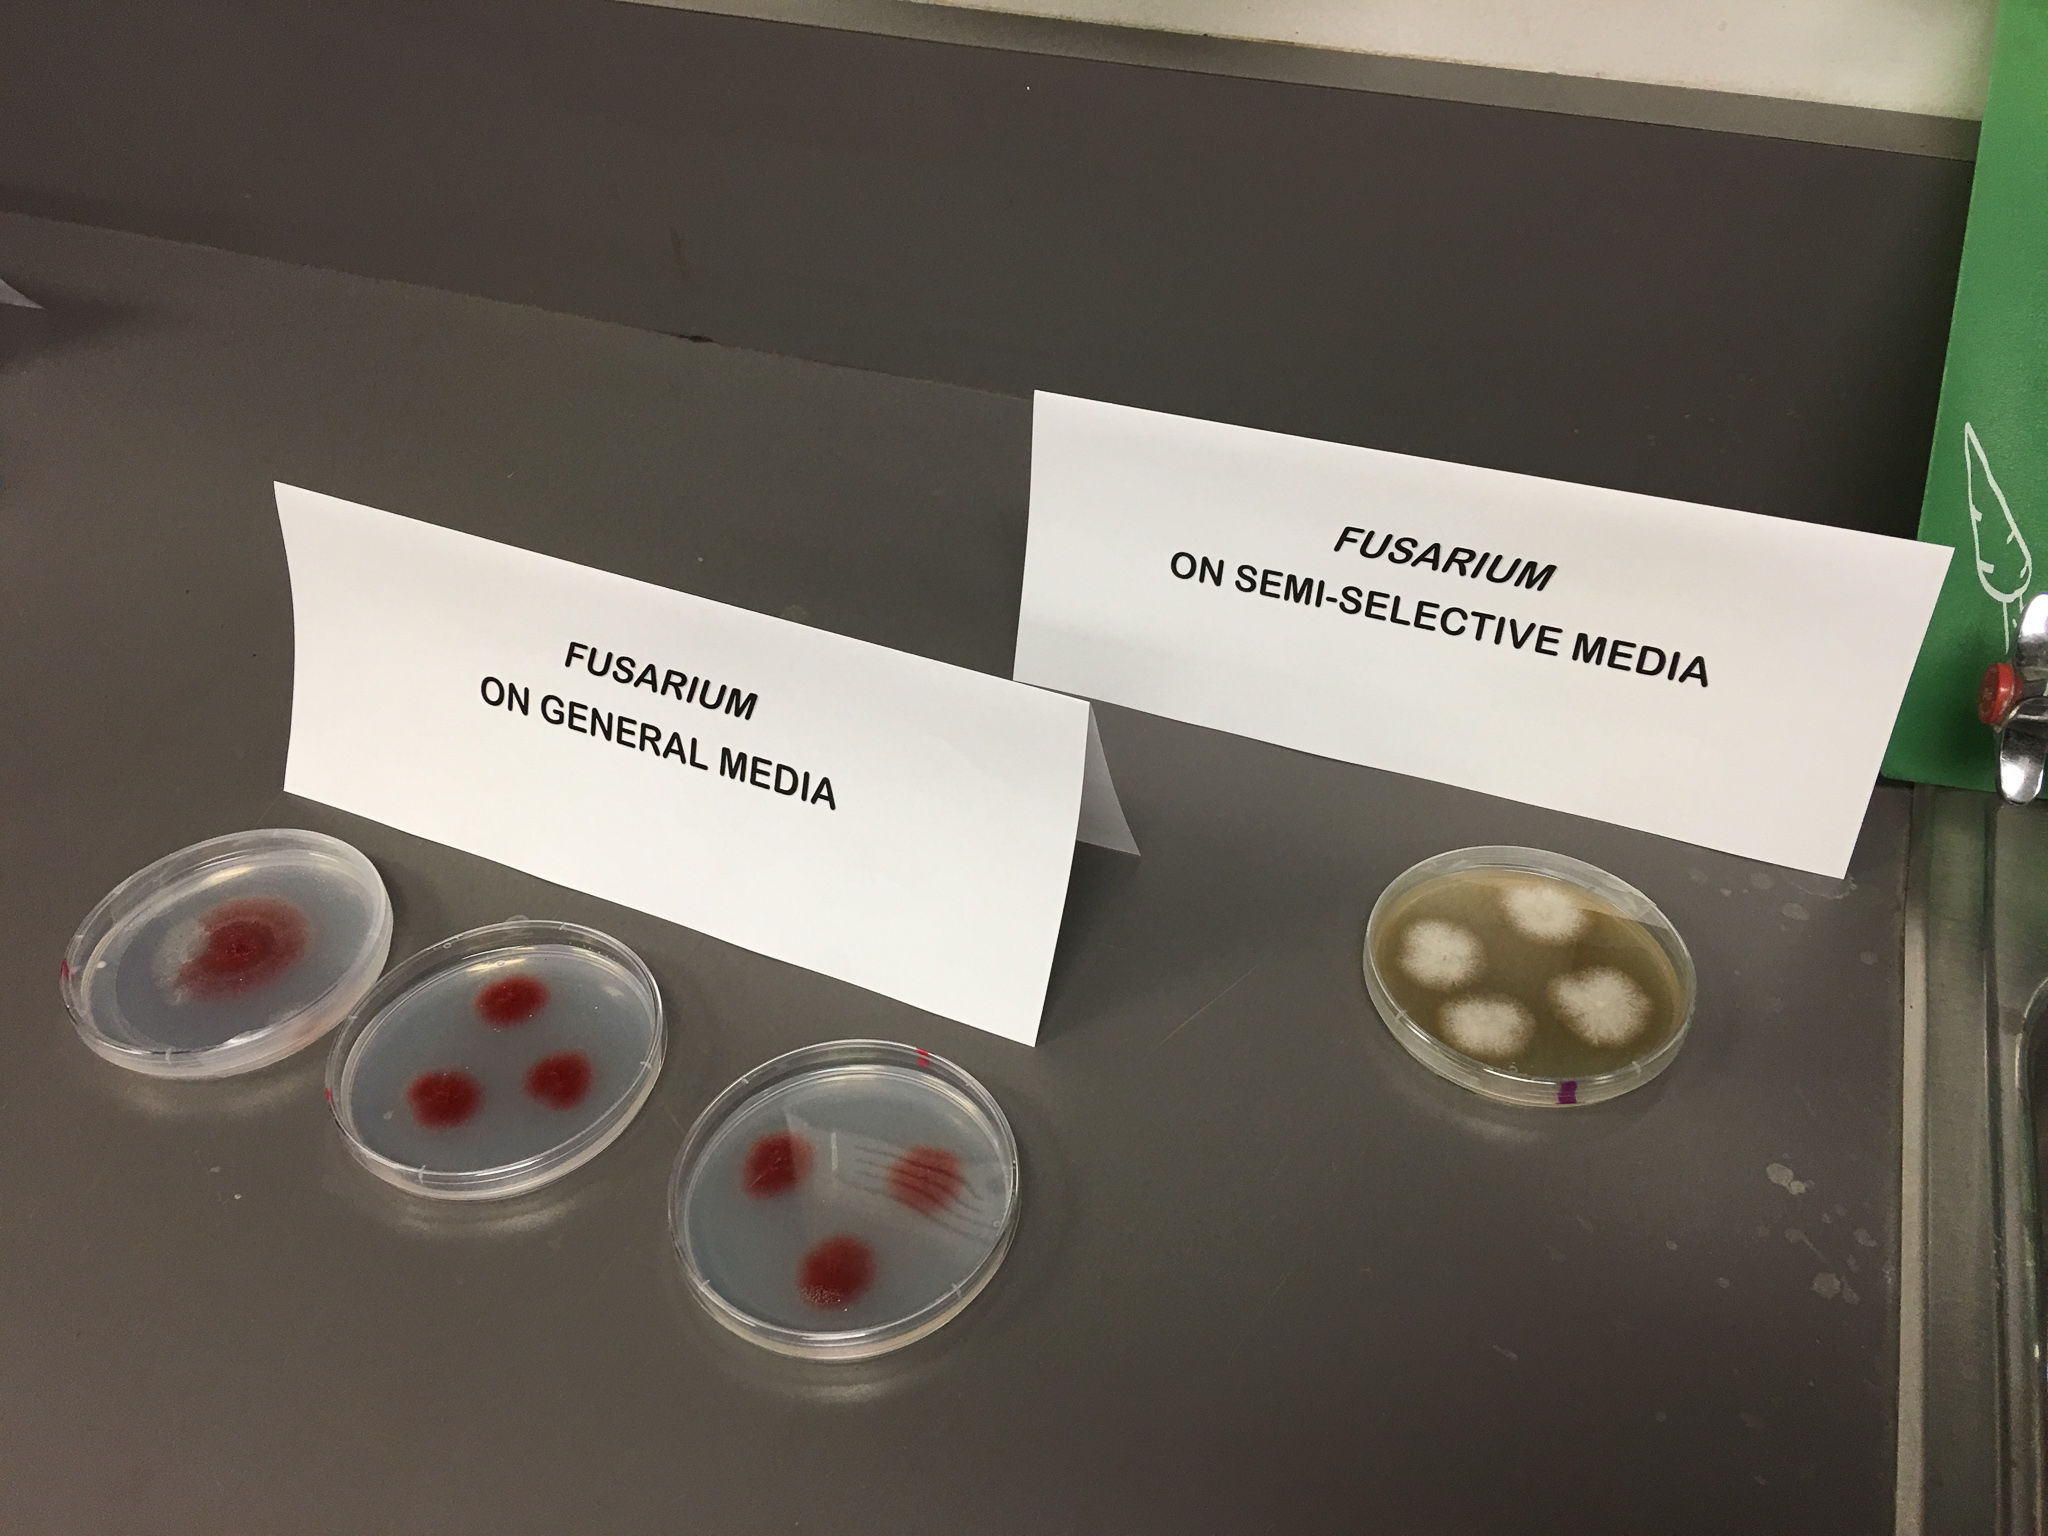

Advancing Management of Fusarium Wilt of Lettuce Conference
Fusarium wilt of lettuce follow up meeting
When
8 a.m. – Noon, Oct. 3 – 4, 2016
Survey results from the 2015 International Symposium on Fusarium Wilt of Lettuce are in! Join us in Monterey, California as we discuss moving forward in the fight against Fusarium wilt of lettuce and tour the Salinas area lettuce industry and research institutions.